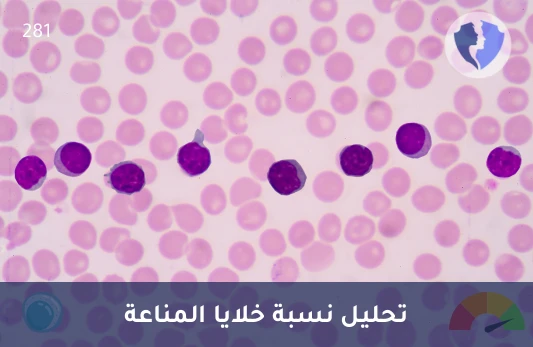
فحص كفاءة الخلايا التائية - تحليل نسبة خلايا (CD3/CD4)

تفاصيل الخدمة
فحص كفاءة الخلايا التائية - تحليل نسبة خلايا (CD3/CD4)
تحليل CD3/CD4 هو اختبار مخبري يُستخدم لتقييم مستويات الخلايا اللمفاوية T في الدم، حيث يُعتبر CD3 علامة مشتركة على جميع الخلايا اللمفاوية T، بينما يشير CD4 إلى نوع معين منها، وهو المسؤول عن دعم وتعزيز الاستجابة المناعية. تُستخدم نتائج هذا التحليل بشكل رئيسي في تشخيص ومراقبة حالات مثل فيروس نقص المناعة البشرية (HIV) وأمراض المناعة الذاتية، مما يساعد الأطباء على تقييم صحة الجهاز المناعي وتحديد الحاجة للعلاج. يُعتبر هذا التحليل أداة هامة في الطب الحديث لفهم وتوجيه العلاجات المناعية.